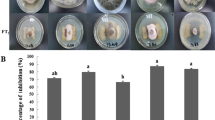

Abstract
The present study tried to explore the possible in vitro biocontrol mechanisms of Lysinibacillus sphaericus, a diazotrophic endophyte from rice against the rice sheath blight pathogen Rhizoctonia solani. The in vivo biocontrol potential of the isolate and the induction of systemic resistance under greenhouse conditions have also been experimented employing different treatments with positive control carbendazim, the chemical fungicide. The endophytic isolate showed 100% growth inhibition of the fungal pathogen via volatile organic compound production and was positive for the production of siderophores, biosurfactants, HCN, and ammonia. Under greenhouse conditions, foliar and soil application of L. sphaericus significantly decreased the percentage of disease incidence. All bacterized treatments are superior to chemical fungicide treatment. Application of L. sphaericus in single and combination treatments induces systemic resistance as evident from the significant accumulation of defense enzymes such as peroxides, polyphenol oxides and phenylalanine ammonia in addition to the increase of phenolic compounds. The results biologically prospect endophytic diazotroph L. sphaericus as a potent plant growth promoter with excellent biocontrol efficiency.
Similar content being viewed by others
Avoid common mistakes on your manuscript.
Introduction
Sheath blight (ShB) of rice, caused by Rhizoctonia solani, accounts for significant yield losses worldwide. Strong sources of genetic resistance are not available for ShB and the disease is currently managed through the use of chemical fungicides (Kumar et al. 2011). Fungicidal management of ShB often gives inconsistent results and is not economical. Indiscriminate use of fungicides and chemical fertilizers to increase rice yields creates several concerns related to environmental hazards, pathogen resistance, leaching losses and the destruction of beneficial microflora. Furthermore, overfertilization of synthetic fertilizers, especially N fertilizers, and intensive tillering are considered as major predisposing factors of the rice sheath blight (Slaton et al. 2003). Even though biological control of the rice sheath blight by various plant growth-promoting rhizobacteria (PGPR) has been well studied, several limitations have been found associated with the use of such PGPRs mainly through exposure to various biotic and abiotic stresses (Malfanova et al. 2011).
The current research focuses on developing endophytic bacteria as potent biocontrol agents, since they can elicit antagonism at the site of infection due to colonization abilities (Hardoim et al. 2008). An endophyte is an endosymbiont that lives inside the host plants without causing any disease. In addition to the basic biocontrol mechanisms like the production of siderophores, HCN, volatile and nonvolatile organic compounds and lytic enzymes, endophytic bacteria are thought to be capable of triggering plant defense mechanisms by a phenomenon known as induced systemic resistance (ISR) (Choudhary and Johri 2009).ISR by endophytic bacteria is known to be triggered by various signaling molecules followed by pathogen invasion. Plants respond to infectious agents by recognizing an array of these microbial signals. Siderophores, lipopolysaccharides, exopolysaccharides, volatiles, flagella, salicylic acid, pyocyanins, etc. are among the reported ISR determinants of endophytic and rhizospheric bacteria (Gupta et al. 2012). These molecular proteins are sufficient to stop infections before pathogen establishment (Akram et al. 2015). Therefore, systemic invasions and colonization by competent endophytes with antagonistic potential can play a major role in the induction of systemic resistance.
The ShB disease incidence of rice occurs only in the late tillering stage and early immunization through free-living bacteria fails to offer disease resistance (Kumar et al. 2011). One of the major predisposing factors for ShB incidence is increased use of N fertilizer. Hence, it is important to develop a nitrogen-fixing endophyte of rice plants with biocontrol activity against ShB disease. Various endophytic bacteria have been reported as biocontrol agents (Liu et al. 2009). Ji et al. (2014) reported the suppression of Sh B disease by a rice endophytic diazotrophic Bacillus subtilis under gnotobiotic conditions. The present study made an attempt to study the putative in vitro biocontrol mechanisms of endophytic diazotrophic bacteria Lysinibacillus sphaericus against the sheath blight pathogen R. solani and to assess the in vivo effects of L. sphaericus in the suppression of rice sheath blight disease under greenhouse conditions.
Materials and methods
Isolation of endophytic nitrogen-fixing bacteria from rice plants
The isolation of endophytic bacteria from rice plants was carried out employing the procedures of Hallmann et al. (2006) with major modifications. Surface-sterilized samples were transferred to Dobereiner’s semisolid N-free Bromothymol blue (BTB) agar for the selective isolation of nitrogen-fixing bacteria and incubated at 28 ± 2 °C for 7 days. The isolates from the positive N-free semisolid media were streaked onto solid N-free Dobereiner’s media amended with 1 M NH4Cl (Gyaneshwar et al. 2001) to get isolated colonies. The selected endophytes were subjected to ARA in a Bruker Gas Chromatograph model GC 450 with flame ionization detector (FID) using nitrogen-free Fahraeus broth (NFFB).
Identification of the isolates
Morphological, cultural and biochemical characteristics of the selected antagonistic endophyte L1, isolated from surface-sterilized leaf tissue were analyzed according to Bergey’s Manual of Systematic Bacteriology. The 16S rDNA typing of the isolate was done using 16S rDNA universal primers: 10–30 F: 50-GAGTTTGATCCT GGCTCAG-30 and 530R: 50-G (AT) ATTACCGCGGCGGCTG-30. The genomic DNA of the isolate was extracted using DNeasy Tissue Kit (Qiagen, Germany) according to the instructions of the manufacturer. The purified amplicon was sequenced using ABI3730xl Genetic Analyzer (Applied Biosystems, USA), and the sequences (16S rDNA) were then used for similarity searches using BLAST (Basic Local Alignment Search Tool) program in the NCBI Gene Bank (www.ncbi.nlm.nih.gov) DNA database for identifying the bacterial strains.
The nif H gene amplification was done according to the procedure described by Balachandar et al. (2006). The genomic DNA was extracted and amplified for nif H using colony PCR techniques. nif Gene was amplified using the following primer sequences: nif H for-5′ TAYGGNAARGGNGGHATYGGYATC and nif H-rev ATRTTRTTNG CNGC RTAVABBGCC ATCAT (Poly et al. 2001). The evolutionary history of 16S rDNA analysis and nif gene amplification was inferred individually using the neighbor-joining method (Tamura et al., 2004). The tree was drawn to scale, with branch lengths in the same units as those of the evolutionary distances used to infer the phylogenetic tree. Phylogenetic analyses were conducted in MEGA4 (Tamura et al. 2007).
In vitro evaluation of endophytic bacteria for biocontrol of Rhizoctonia solani
The rice sheath blight pathogen Rhizoctonia solani Kuhn was obtained from the culture collection center, Department of Plant Pathology, Kerala Agricultural University, Mannuthy, Thrissur, Kerala. The pathogen was maintained by regular subculturing on potato dextrose agar (PDA) slants and kept at 4 °C.
The in vitro antagonistic effect of L. sphaericus was determined using a dual culture plate assay on nutrient agar: PDA agar. The agar well diffusion assay was performed using the culture filtrate of the overnight-grown NB culture of Lysinibacillus sphaericus. The overnight culture was centrifuged at 18,558×g for 10 min and the cell free supernatant was used for determining the antifungal activity using the well diffusion assay. A 5 mm mycelial disc of 5-day-old test pathogen was placed in the center of the set nutrient agar: PDA agar plates. Two wells, each about 5 mm in diameter, were made by punching the agar with a sterile steel cork borer on either side of the pathogen inoculums and 100 μl of the culture filtrate was incorporated into the wells. The plates were incubated for 7 days at 28 ± 2 °C and the inhibitory activity of the culture filtrate was expressed as the percent growth inhibition, compared to the control kept with the sterile supernatant of centrifuged nutrient broth alone incorporated in the wells. The experiment was repeated thrice with three replications.
In vitro analysis of putative biocontrol mechanisms
Putative biocontrol mechanisms of the selected antagonistic endophyte L1 was assessed in vitro. Qualitative detection of siderophores was done by ferric chloride test according to Suryakala et al. (2004). Quantitative estimation was also done by employing the procedure described by Adhikari et al.(2013). The quantity of siderophores synthesized was expressed as µmol benzoic acid mL−1 of the cell free culture filtrate (CFCF). Hydrocyanic acid (HCN) production by the isolates was tested by the method of Miller and Higgins (1970). The production of volatile organic compounds was observed by the paired bottom plate method and that of nonvolatile and/or diffusible organic compounds was done by using CFCF of the isolate studied, adopting well diffusion assay as described elsewhere. Observations were made for the absence of sclerotium germination and the percentage of reduction in the growth of R. solani in the control and test plates.
The in vitro β 1,3 glucanase activity was measured according to the procedure described by Rajendran et al. (2007) using cell-free culture filtrate. The amount of reducing sugar was calculated from the glucose standards and the activity of β 1,3 glucanase was expressed in nkat mL−1. One nkatal corresponds to 1 nmol of glucose equivalents per seconds. In vitro chitinase activity was also measured using the culture filtrate prepared in the above section. The chitinase activity was expressed as equivalents of N-acetyl glucosamine (GlcNAc, Hi Media) kept as standard.
Biocontrol efficiency under greenhouse conditions
The biocontrol efficiency of L. sphaericus against R. solani was assessed under greenhouse conditions, using various treatments (Table 3).Rice seeds of crop variety ponmani were obtained from the State Seed Farm, Okkal, Perumbavoor, run by Kerala Agricultural University. The experiment was arranged in a completely randomized design (CRD) and was repeated thrice with three replications per treatment.
Pot preparation
Soil from rice farming fields (loamy texture, pH 4.68; electrical conductivity, 0.031 ds M−1; organic carbon, 1.92%: available nitrogen, 128 kg ha−1; available phosphorus, 4.30 kg ha−1; available potassium, 85.12 kg ha−1; dehydrogenase activity 1.36 µg TPF soil day−1) was air dried and passed through a 2 mm sieve. Fertilizer recommendations as per POP, Kerala Agricultural University, include urea at the rate of 123 kg ha−1, Raj phosphate at the rate of 260 kg ha−1, muriate of potash at the rate of 87 kg h−1 and lime or dolomite 240 kg ha−1. Fertilizers at the rate mentioned were weighed separately for each pot and mixed with soil and filled in pots (27 × 25 cm) at the rate of 10 kg per pot. N was applied at half rates from the recommended dose and in three equal splits: as basal dose at tillering and final dose after panicle initiation. The P and K fertilizers were applied entirely as per recommendations as basal dose. Lime was applied at two split doses before sowing and 1 month after sowing.
Preparation of L. sphaericus inoculum and mode of application in greenhouse experiments
Rice seeds of the variety ponmani were surface sterilized with 2% sodium hypochlorite for 3 min and washed with sterile distilled water five times. Seeds were divided into approximately two equal parts; part A and part B. Seeds from part A were selected for bacterization with endophytic isolate L. sphaericus and fungicide Bavistin 50DF (carbendazim 50%DF manufactured by Biostadt India Ltd) treatment. Surface-sterilized seeds of part B were meant for seedling germination in nursery beds and control experiments. Nursery beds were prepared for all treatments other than seed treatment. For this, randomly selected surface-sterilized seeds from part B were dipped in pre-sterilized tap water in sterile Petri plates for pre-germination in warm condition for 3 days. Pre-germinated seeds were allowed to grow in nursery beds for the next 18 days by maintaining an optimum water regime under proper climatic conditions in a greenhouse.
For seed treatment, randomly selected surface-sterilized seeds from part A were soaked in 24-h-old NB culture (2 × 108 cfu mL−1) of L. sphaericus and incubated for 24 h at room temperature. Thereafter, seeds were air dried in the laminar airflow chamber for 30 min. The seeds were directly transferred to the already prepared potted soil. Four 5 cm digs were made in each pot and each dig received randomly selected five bacterized seeds. Seed-treated pots were prepared separately for combination treatments T7–T12. The positive chemical control carbendazim was also treated with seeds at the rate of 5 g kg−1 of seeds (Rajendran and Samiyappan 2008).
For soil inoculation, also 24-h-old 5 mL standard inoculum (2 × 108 cfu mL−1) of L. sphaericus was used. 21-day-old seedlings were uprooted from the nursery bed and washed several times with sterilized water and transplanted onto each pit in the pots. Another set of 21-day-old seedlings from the nursery was transplanted to furrowed pots in a similar manner without inoculation. This setup was meant for foliar spray treatments. For foliar spray treatments, 10 mL of 24-h-old inoculum (2 × 108 cfu mL−1) was diluted with 90 mL of tap water and used for an application. Foliar treatment was given on 30 days of plant age, prior to challenge inoculation with the pathogen. Foliar application of fungicide carbendazim was also done in a similar manner at a concentration of 0.1% at similar plant ages.
For the combination of seed treatments, the second set of seed-treated plants received 5 ml standard inoculum in the soil at 21 days of plant age (T7) in addition to seed treatment (T1). In T9, the 30-day-old plants received a foliar treatment in addition to the seed treatment. For treatments T11, the soil-inoculated plants received a foliar application on the 30th day of plant age. Carbendazim was also applied in a similar manner for treatments T8, T10 and T12, respectively. The plants were watered twice a day to maintain optimum soil moisture regime and kept under greenhouse conditions with ambient irradiance, temperature and humidity. The humidity in the green was maintained at around RH 80%. Control plants did not receive any biotization or chemical treatment at any stages of plant growth.
Pathogen inoculation
The ShB was artificially introduced by challenge inoculation on the 45th day of plant age, according to the methods described by Kumar et al. (2011) with minor modifications. Sclerotia of fungal pathogen R. solani, grown on PDA plates as described, served as a source of pathogen inoculum. The leaf sheaths of 45-day-old plants at 2 cm above water level were carefully opened and inoculated with sclerotia at the rate of one sclerotium per plant. After inoculation, the pots were covered with polyethylene sheeting for 5 days to maintain high humidity (>95%), which favored disease development. The minimum and maximum temperatures were 19 ± 2 and 30 ± 2 °C, respectively, during the experiment period. The lesion length was measured after 15 days of challenge inoculation and lesion size was calculated by multiplying with length and width of lesions.
The percent sheath blight intensity (SBI) was determined using the following formula:
Effect of L. sphaericus in the induction of defense enzymes against R. solani
The role of endophytic diazotrophic L. sphaericus in induced systemic resistance (ISR) of rice plants against rice sheath blight pathogen R. solani was assessed under greenhouse conditions. Plant seeds treated with chemical fungicide Bavistin 50DF (carbendazim 50%DF manufactured by Biostadt India Ltd) were kept as a positive standard chemical control for comparison. Plants developed from uninoculated seedlings from the same nursery bed prepared for biocontrol efficiency were used as healthy untreated controls. Plants belonging to the same criteria, but challenge inoculated with the fungal pathogen R. solani on the 45th day of plant age, served as pathogen control (T8). Here also, the pots were arranged in CRD (completely randomized design) and the experiments repeated thrice with three replications. The pots and plants were prepared as per the methods described for biocontrol efficiency. Greenhouse conditions and watering were also maintained under the same conditions. The mode of pathogen inoculation also followed a similar methodology.
Sample collection and extraction
Leaf samples from each experiment were carefully excised at different time intervals, viz., 24, 48 and 72 h, after pathogen inoculation, homogenized with liquid nitrogen in a pre-chilled mortar and pestle and kept at −80 °C until analysis. The increased activity of enzymes such as peroxidase (PO), polyphenyl oxidase (PPO), phenylalanine ammonia-lyase (PAL), chitinase and β 1,3 glucanase were tested spectrophotometrically using a UV–Vis spectrophotometer. In addition, the effect of L. sphaericus in the induction of total phenolic content was also measured. All experiments were done according to the procedures described by Rajendran and Swamiyappan (2008).
Assay of peroxidase (PO)
Leaf samples from each treatment were homogenized in 3 mL 0.1 M phosphate buffer solution (pH 7.0) at 4 °C. The homogenate was centrifuged at 20,070×g at 4 °C for 15 min and the supernatant was used as enzyme source. The reaction mix consisted of 0.05 mL pyrogallol, 0.5 mL enzyme extract and 0.5 mL 1% hydrogen peroxide. The reaction mix was mixed well and incubated at room temperature. The changes in absorbance at 420 nm were recorded at 30 s intervals for 3 min. The enzyme activity was expressed as changes in the absorbance of the reaction mixture min−1 g−1 fresh weight.
Assay of polyphenol oxidase (PPO)
One gram of leaf samples from each treatment was homogenized in 2 mL of 0.1 M sodium phosphate buffer at pH 6.5 and centrifuged at 20,070g for 15 min at 4 °C. The supernatant was used as the enzyme source. The reaction mix included 200 µL of enzyme extract and 1.5 mL of 0.1 M sodium phosphate buffer at pH 6.5. The reaction was allowed to start by adding 200 µL of 0.01 M catechol and the enzyme activity was measured at 495 nm as changes in absorbance min−1 g−1 fresh weight.
Assay of phenylalanine ammonia-lyase (PAL)
The assay mixture for PAL consisted of 100 µL enzyme extract, 500 µL of 50 mM Tris–HCl (pH 8.8) and 600 µL of 1 mM l-phenylalanine. The reaction mix was incubated at room temperature for 60 min and was stopped by adding 2 N HCl. After that, 1.5 mL of toluene was added and vortexed for 30 s and centrifuged at 78×g for 5 min. The toluene fraction containing the trans-cinnamic acid was separated and measured at 290 nm against a toluene blank. The enzyme activity was calculated using a standard graph plotted against different concentrations of cinnamic acid in toluene and expressed as n moles trans-cinnamic acid min−1 gm−1.
Assay of β 1,3 glucanase activity
β 1,3 glucanase activity was assayed by the laminarin–dinitrosalicylate method. One gram of leaves was extracted from each treatment with 5 mL of 0.05 M sodium acetate buffer (pH 5.0) by grinding at 4 °C using a mortar and pestle. The extract was centrifuged at 20,070×g for 15 min at 4 °C and the supernatant was used as the enzyme source. The reaction mixture consisted of 62.5 μL of 4% laminarin and 62.5 μL of enzyme extract. The reaction was carried out at 40 °C for 10 min and stopped by adding 375 μL of dinitrosalicylic reagent and heating for 5 min in a boiling water bath. The resulting colored solution was diluted with 4.5 mL of distilled water, vortexed and the absorbance was measured at 500 nm. The enzyme activity was expressed as µg glucose released/min/g fresh weight.
Assay of chitinase activity
Chitinase enzyme activity was assayed spectrophotometrically using colloidal chitin (see Appendix) as substrate. One gram of leaf sample from each treatment was homogenized in 2 mL of 0.1 M sodium citrate buffer (pH 5.0). The homogenate was centrifuged at 7840×g for 15 min at 5 °C, and 0.4 mL supernatant was added to the reaction mixture consisting of 10 µL of 0.1 M sodium acetate buffer (pH 4) and 0.1 mL of colloidal chitin. After incubation of 2 h at 37 °C, the reactions were stopped by centrifugation at 78×g for 3 min. 0.3 mL of the supernatant was pipetted into the glass reagent tube containing 30 µL of 1 M potassium phosphate buffer (pH 7) and incubated with 20 µL of 3% (v/v) snail gut enzyme for 1 h. After 1 h, the mixture was brought to pH 8.9 by adding 70 µL 0.1 M sodium borate buffer (pH 8.9). The mixture was incubated in a boiling water bath for 3 min, followed by rapid cooling in ice. The mixture was incubated for 20 min at 37 °C immediately after the addition of 2 mL DMAB. The absorbance was measured at 585 nm. N-acetyl glucosamine (GlcNAc) (HI Media) was used as the standard and the enzyme activity was expressed as GlcNAc equivalent−1 g−1 fresh weight.
Assay of total phenolic content
One gram of leaf tissue from each treatment was homogenized in 10 mL of 80% methanol (HiMedia) using a mortar and pestle. It was mixed well and agitated in a water bath shaker for 15 min at 70 °C. 1 mL of this methanolic extract was added to a mixture of 5 mL distilled water and 250 µL 1 N Folin–Ciocalteu reagent. The solution was kept at 25 °C for 3 min. After incubation, 1 mL of the saturated solution of sodium carbonate and 1 mL of distilled water were added to the reaction mix and incubated for 1 h at 25 °C. The absorbance of the blue color that developed was measured at 725 nm. The total soluble phenol was calculated from standard graph drawn and expressed as catechol g−1 fresh weight.
Statistical analysis
Data from repeated laboratory and greenhouse studies were analyzed separately and subjected to analysis of variance (ANOVA) (SPSS Software) and the least significant difference test (LSD) was performed to separate the group means when ANOVAs were significant at P ⩽ 0.05. The means were compared by Duncan’s multiple range test using the statistical package SAS version 8.3 (SAS Institute Inc., Cary, NC, the USA).The alphabets, given as superscripts in the tables denote ranking of treatments based on Duncan’s multiple range test.
Results
Identification of the endophytic diazotroph
The isolate L1 was identified as L. sphaericus based on its morphological, biochemical and genotypic characteristics. BLAST analysis revealed 99.9% sequence similarity with L. sphaericus. The 16S rRNA amplicon was deposited in the National Center for Biotechnology Information (NCBI) GenBank under Accession Number KJ 872548. The nif genes were shown to be nif H specific by BLAST analysis and sequence similarity search in NCBI GenBank. The sequences of nif H amplicons were deposited in the NCBI GenBank with Accession Number KR133403.
Putative in vitro biocontrol mechanisms
The endophytic diazotrophic isolate L. sphaericus was able to produce siderophores (17.85 ± 0.04 µmol/mL Culture filtrate). The isolate showed 100 and 76% of growth inhibition in volatile and nonvolatile organic compound production, respectively. HCN production was positively detected by the change in color of filter paper dipped in picric acid solution. In vitro production of β 1,3 glucanase and chitinase by the antagonist L. sphaericus was 0.08 ± 0.02 mg mL−1 glucose and 2.2 ± 0.03 mg ml−1 N-acetyl glucosamine (Table 1). The positive reaction in qualitative drop collapsing test was confirmed quantitatively by a higher emulsification index (E24) of 9.09 ± 0.004 and 7.4 ± 0.04 in both the medium tested, proving the production of biosurfactants (Table 2).
Induction of defense enzymes
Studies on the induction of defense enzymes revealed that upon pathogen inoculation, higher amounts of defense enzymes were expressed in bacterized rice plants in comparison to non-bacterized plants. In all the experiments, foliar treatments resulted in the highest enzyme production during 24 h past inoculation both in single and combination treatments. In general, the pattern of enzyme induction was found to reach the maximum during 24 h of time intervals and thereafter declined gradually. The PO activity was found to vary according to the time intervals of sampling. Plants which received bacterial application as foliar treatment (T3) showed the highest PO activity, followed by combination treatments T4 and T5. Plants treated with fungicide carbendazim also showed induction of PO activity (Fig. 1). The PO activity was found to decrease toward 72 h after challenge inoculation with fungal pathogen and in plants without any treatment.
The PPO enzyme activity was found to increase at 24 h after challenge inoculation in all treatments considerably. The activity tends to be decreased 48 and 72 h after challenge inoculation. The highest PPO activity at 24 h was shown by T3 (0.39 min−1 g−1) and is statistically at par with treatment T6 (0.38min−1 g−1). At 72 h, the treatments T1 and T7, which received seed treatment of L. sphaericus and carbendazim, showed significant hike in PPO activity (Fig. 2) The highest PAL activity at all time intervals was given by foliar treatments alone and in combination with seed and soil (Fig. 3). Plants treated with fungicide carbendazim also showed induction of PAL similar to bacterized plants in the time course, but at lower levels. Uninoculated healthy controls showed a linear decrease in PAL activity at 24, 48 and 72 h.
Induction of chitinase enzyme by endophytic bacteria in rice plants challenged with R. solani did not show much variation among different treatments under greenhouse conditions. Increase in chitinase activity was detected in appreciable amounts both 24 and 48 h after treatment and then declined (Fig. 4). The highest chitinase enzyme activity at 24 h after treatment was shown by rice plants treated with (T7) chemical fungicide carbendazim (30.12 mgGlcNAc−1 g−1 fresh weight), followed by foliar treatment (T3) (29.43 mgGlcNAc−1 g−1 fresh weight). All the treatments, including the positive control carbendazim, showed very minute level of induction of β 1,3 glucanase enzyme activity at 24, 48 and 72 h of sampling (Fig. 5). Very low and statistically similar values were noticed in both the control plants, viz., disease control (T8) which did not receive any treatment and healthy control plants without challenge inoculation (T9). In general, an increase in enzyme activity was shown by all treatments at 48 h from that of 24 h after challenge inoculation. The enzyme activity was found to be declining at 72 h after challenge inoculation. In addition, accumulation of phenols was found to start after 24 h of treatment and remained more or less constant in all treatments challenge inoculated with R. solani, except for foliar treatments. In foliar treatments, phenolic accumulation was shown to be decreased toward 72 h of treatment and all results were significantly higher than those of the control plants (Fig. 6).
Biocontrol efficiency under greenhouse conditions
Rice diazotrophic endophyte L. sphaericus effectively controlled the rice sheath blight disease with less variation in % DI and % DS. Treatment T3, which received an application of L. sphaericus in the form of a single foliar spray, showed the highest % DI and % DS (5.20 and 84.75%, respectively), which is found to be statistically on par with treatment T2 with soil applications of L. sphaericus (6.36 and 81.35%, respectively).The positive control carbendazim showed only 67.4 and 64.83% DS and 11.15 and 12.65% DI, respectively, for the same treatments. This shows the superiority of endophytic L. sphaericus as efficient colonizers and the ineffectiveness of chemical fungicides.
The application of L. sphaericus in combination treatments did not show much variation. The highest % DS among treatments in combination was given by T4, i.e., seed plus soil (80.56%). The treatments T5 and T6 showed 81.14 and 80.94%, respectively. Control plants which did not receive any biological or chemical treatment showed 34.07% of DS, confirming the potential of endophytic diazotrophic L. sphaericus in the suppression of rice sheath blight effectively (Table 3).
Discussion
Beneficial plant microbial interactions offer great opportunities for sustainable agriculture. Eco-friendly management of crop diseases has been practised for many years extensively using PGPRs. As competent endophytes are evolved from potent root colonizers among PGPRs, the use of endophytic bacteria gains significant attention in effective and localized biocontrol (Hardoim et al. 2008; Gupta et al. 2012).The production of various allelochemicals and induced systemic resistance are the major mechanisms of action involved in biological control. Many reports are available with biocontrol abilities of endophytic bacteria isolated from diverse hosts, mainly belonging to Bacillus sp. (Yang et al. 2011; Wang et al. 2009; Rajendran and Swamiyappan 2008). Ji et al. (2014) reported the antagonistic effects of endophytic diazotroph Bacillus subtilis against R. solani in rice. In their exclusive review, Gupta et al.(2012) describe that volatile organic compound production plays a major role in the biocontrol of plant pathogens via induction of systemic resistance. In the present study, 100% inhibition of mycelial growth could be observed in the volatile organic compound production. Bacillus sp. has been found to produce exceptional biocontrol activities due to volatile organic compound production (Solanki et al. 2015; Norman et al. 2011). Strobel (2006) reported the biocontrol efficiency of a volatile organic compound, 2,3-butanediol from endophytic Bacillus spp.
Microbial biosurfactants have been known to play a significant role in antifungal activities. Biocontrol activity of biosurfactants is due to detergent-like activity in dissolving cell wall lipid membrane, resulting in the loss of cell integrity and viability. Ongena et al. (2005) reported surfactants as elicitors of induced systemic resistance in plants by bacteria against phytopathogens. Microorganisms use the ability of hydrolytic enzyme production, such as cellulase, amylase, pectinase, chitinase, β 1, 3 glucanase and xylanase, primarily as the mechanism of biocontrol. By producing these lytic enzymes, they can cleave the cell walls of fungal pathogens and cause mycelial destruction. Many plant growth-promoting endophytic bacteria are reported to produce in vitro lytic enzymes (Amaresan et al. 2014). As far as endophytes are considered, the production of lytic enzyme plays other important roles in vertical spreading and secondary cell wall lysis of host plants, enabling colonization and endophytic establishment (Hurek and Hurek 2003).
Siderophore production by diazotrophic bacteria is a key phenomenon of metal chelation under iron-deficient condition, since the nitrogen-fixing enzyme nitrogenase requires both iron and molybdenum for activity (Gupta et al. 2012). Siderophores produced by biocontrol bacteria have a higher affinity for iron than the siderophores produced by fungal pathogens, allowing the antagonistic bacteria to scavenge most of the available iron and thereby prevent a proliferation of fungal pathogens. Ji et al. (2014) recently reported the endophytic diazotrophs Klebsiella pneumoniae, B. subtilis and Microbacterium sp., which showed antagonism toward R. solani as siderophore producers. Ammonia production by bacteria plays many roles in plant physiology and plant growth promotion and is produced mainly through nitrite ammonification in diazotrophic bacteria (Geetha et al. 2014). It acts as an antagonistic factor against phytopathogens also in combination with HCN and siderophore production (Allu et al. 2014). Hardoim et al. (2008) reviewed that host plants play a major role in the selection of a bacterium to be an endophyte. Therefore, it is clear that the production of siderophores, ammonia and lytic enzymes by the diazotrophic isolate L. sphaericus is beneficial to the plant and to the bacterium itself, revealing its endophytic and symbiotic lifestyle.
Inducing a plant’s own defense mechanism by prior application of a biological agent is an emerging concept and strategy in plant defense mechanism. Induced resistance is a physiological ‘‘status of improved defensive capacity’’ elicited by specific environmental stimuli, whereby the plant’s innate defenses are potentiated against subsequent biotic challenges (van Loon 2000). Various signals from bacteria can act as ISR elicitors, including LPS, flagella, siderophores, antibiotics, volatile organic compounds and quorum signaling (van Loon et al. 2006. This is proved by the trends of increased accumulation of all defense enzymes, PR proteins, and phenolic compounds after 24 h of pathogen inoculation in the bacterized plants in ISR studies of L. sphaericus.
The role of PO, PPO and PAL in ISR studies has been documented by various authors against R. solani and other fungal pathogens in rice and other diverse crops (Chitrasree et al. 2011; Rajendran and Samiyappan 2008; Jayaraj et al. 2004). PAL is the key biosynthetic enzyme for a variety of plant secondary metabolites and plays a major role in phenolic compound accumulation (Zdor and Anderson 1992). The present study showed increased cinnamic acid accumulation in all treatments in a considerable manner. Cinnamic acid production actively occurs under pathogen stress and also acts as a precursor for the synthesis of phenolic compound ferulic acid from phenylalanine through the phenyl propanoid pathway catalyzed by PAL. In this study, total phenolic accumulation was also found to vary in accordance with PAL accumulation. The PAL accumulation in healthy control plants was higher compared to phenolic accumulation. This can be justified by an argument that phenolic compounds are involved in antifungal activities too. In healthy plants, signals for phenolic accumulation may be absent due to lack of challenge inoculation and bacterization. These highlight and confirm the role of introducing endophytic bacteria L. sphaericus in induction of defense mechanisms.
Chitinase accumulation was found to be greater in response to pathogen invasion and might contribute to increased plant resistance. Similar results are reported by (Shrestha et al. 2008; Rajendran and Samiyappan 2008; Radiacommare et al. 2004) in rice plants. This is in contradiction to the in vitro experiments where chitinase production was absent in plate assay and estimations. This may be due to the expression of plant genes for chitinase. It is also clear from the data that in the uninoculated disease control, chitinase level was lower compared to inoculated and challenged plants. Hence, it can be assumed that the in vivo production of chitinase enzyme happened due to the combined action of L. sphaericus and plant genome. Furthermore, enhanced chitinase accumulation was found after 48 and 72 h. Since the chemical carbendazim acts as a common elicitor for all defense enzymes, this change in accumulation of chitinase in the bacteria-treated plants might be due to selective response to fungal chitins. In contrast, β 1,3 glucanase levels were found to be very low compared to chitinase levels. Since the fungal cell wall of R. solani is made up of chitin alone and no glucan, the plant might have expressed chitinase only (Shrestha et al. 2008). (Leeman et al. 1995) reported the need of a 2 days’ time interval between antagonistic application and challenge inoculation for the execution of ISR. However, small amounts of defense enzymes and PR proteins can be found in association with all treatments on healthy uninoculated plants. Shrestha et al. (2008) describe this may be due to the exposure of plants to low levels of stress under most types of growth conditions.
The greenhouse experiment results emphasized the superiority of endophytic microbial application over harmful chemical fungicide carbendazim. The statistically significant results found in this study nominate the replacement of chemical disease control by eco-friendly and cost-effective use of potential endophytic diazotroph L. sphaericus. All the treatments with L. sphaericus in single or combination mode found statistically similar and highest disease suppression by foliar application followed by soil application. This may be because foliar treatment was given as the nearest application prior to challenge inoculation, resulting in enhanced proliferation and metabolic activities in the leaf cells. There are possibilities for translocation of bacteria from leaf tissues of the nearest aerial part stem. All these might have contributed to effective disease suppression. There are reports on effective biocontrol of R.solani by Bacillus subtilis as a foliar application (Liu et al. 2009).
Berg and Hallmann (2006) reported that the expression of antifungal mechanisms by endophytic bacteria is strain specific. A number of Bacillus sp. have been described as biocontrol agents toward R. solani, but the majority of them belong to soil or rhizosphere groups characterized by limited internal colonization. Several strains of the species Bacillus amyloliquefaciens, B. subtilis, B. pasteurii, B. cereus, B. pumilus, B. mycoides, and B. sphaericus have been reported to possess significant reductions in the incidence or severity of various diseases on a diversity of hosts in pot and field experiments (Kumar et al. 2011; Choudhary and Johri 2009). L. sphaericus which belongs to Bacillus sp., formerly known as B. sphaericus (Ahmed et al. 2007), are well-known commercial mosquitocidal agents also (Berry 2012).This is the first report on the in vitro and greenhouse biocontrol ability and induced systemic resistance of endophytic diazotroph L. sphearicus against R. solani. As it is an endophytic spore-forming bacillus and a well-known commercially available pesticidal agent, research on better formulations and field experiments can explore it as a propitious candidate for the eco-friendly management of rice sheath blight and sustainable agriculture.
References
Adhikari A, Dutta S, Bhattacharya I, De Roy M, Sarkar G, Mandal T (2013) Antagonistic potentiality of native rhizobacterial isolates against root rot disease of okra, incited by Rhizoctonia solani. Afr JAgric 8(4):405–412
Ahmed I, Yokota A, Yamazoe A, Fujiwara T (2007) Proposal of Lysinibacillus boronitolerans gen. nov. sp. nov., and transfer of Bacillus fusiformis to Lysinibacillus fusiformis comb. nov. and Bacillus sphaericus to Lysinibacillus sphaericus comb. nov. Int J Syst Evol Microbiol 57(5):1117–1125
Akram W, Anjum T, Ali B (2015) Searching ISR determinant/s from Bacillus subtilis IAGS174 against Fusariumwilt of tomatoe. BioControl 60:271–280
Allu S, Kumar NP, Audipudi AV (2014) Isolation, biochemical and PGP characterization of endophytic Pseudomonas aeruginosa isolated from chilli red fruit antagonistic against chilli anthracnose disease. Int J Curr Microbiol App Sci 3(2):318–329
Amaresan N, Jayakumar V, Thajuddin N (2014) Isolation and characterization of endophytic bacteria in chilli grown in coastal agricultural ecosystem. Indian J Biotech 13:247–255
Balachandar D, Sandhiya GS, Sugitha TCK, Kumar K (2006) Flavonoids and growth hormones influence endophytic colonization and in planta nitrogen fixation by a diazotrophic Serratia sp. in rice. World J Microbiol Biotechnol 22:707–712
Berg G, Hallmann J (2006) Control of plant pathogenic fungi with bacterial endophytes. In: Barbara E, Schulz JE, Christine, Boyle JC, Sieber TN (eds) Microbial root endophytes, pp 53–69
Berry C (2012) The bacterium, Lysinibacillus sphaericus, as an insect pathogen. J Invertebr Pathol 109:1–10
Chitrasree AC, Udayasankar S, Reddy MS, Srinivas C (2011) Plant growth promoting rhizobacteria mediated induced systemic resistance in rice against bacterial leaf blight caused by Xanthomonasoryzaepv.oryzae. Biol Control 59:114–122
Choudhary DK, Johri BN (2009) Interactions of Bacillus sp. and plants with special reference to induced systemic resistance (ISR). Microb Res 164:493–513
Geetha J, Venkatesham E, Hindumathi A, Bhadraiah B (2014) Isolation, screening and characterization of plant growth promoting bacteria and their effect on Vigna Radita (L.) R. Wilczek. Int J Curr Microbiol Appl Sci 3(6):799–803
Gupta G, Panwar J, Akhtar MS, Jha NP (2012) Endophytic nitrogen fixing bacteria as biofertilizer. In: Lichtfouse E (ed) Sustainable agriculture reviews 1. Springer, Cham, pp 183–221
Gyaneshwar P, James EK, Mathan N, Reddy PM, Reinhold-Hurek B, Ladha JK (2001) Endophytic colonization of rice by a diazotrophic strain of serratia marcescens. J Bacteriol 183(8):2634–2645
Hallmann J, Berg G, Schulz B (2006) Isolation procedures for endophytic microorganisms. In: Barabara E, Schulz JE, Christine, Boyle JC, Sieber TN (eds) Microbial root endophytes. Springer, pp 299–319
Hardoim PR, van Overbeek LS, Elsas JD (2008) Properties of bacterial endophytes and their proposed role in plant growth. Trends Microbiol 16:463–471
Hurek T, Hurek BR (2003) Azoarcussp. strain BH72 as a model for nitrogen-fixing grass endophytes. Biotech 106:169–178
Jayaraj J, Liang GH, Muthukrishnan S, Velazhahan R (2004) Foliar application of Bacillus subtilisAUBS1 redces sheath blight and triggers defense mechanism in rice. J Plant Dis Prot 11(2):115–125
Ji SH, Gururani MA, Chun SC (2014) Isolation and characterization of plant growth promoting endophytic diazotrophic bacteria from Korean rice cultivars. Microbiol res 169(1):83–98
Kumar KVK, Reddy MS, Yellareddygar SKR, Kloepper JW, Lawrence KS, Zhou XG, Miller ME (2011) Evaluation and selection of elite plant growth-promoting Rhizobacteria for suppression of sheath blight of rice caused by Rhizoctonia solani in a detached leaf bio-assay. Int J Appl Biol Pharma Technol 2(1):488–495
Leeman M, Van Pelt MJ, Hendrickx RL, Scheffer RJ, Bakker PAHM, Schippers B (1995) Biocontrol of fusarium wilt of radish in commercial greenhouse trials by seed treatment with Pseucdomonas fluorescens strains WCS374. Phyto Pathol 85:1301–1305
Liu B, Qiao H, Huang L, Buchenauer H, Han Q, Kang Z, Gong Y (2009) Biological control of take in all wheat by endophytic Bacillus subtilis E1R-j and potential mode of action. Biol Control 49:277–285
Malfanova N, Kamilova F, Validov S, Shcherbakov A, Chebotar V, Tikhonovich I, Lugtenberg B (2011) Characterization of Bacillus subtilis HC8, a novel plant-beneficial endophytic strain from giant hogweed. Microb Biotechnol 4(4):523–532
Norman DJ, Dickstein ER, Yuen JMF (2011) Inhibition of Rhizoctonia by endospore forming bacteria indigenous to landscape planting beds. Biocontrol Sci Technol 21:1133–1142
Ongena M, Jourdan E, Schafer M, Kech C, Budzikiewicz H, Luxen A, Thonart P (2005) Isolation of an N-alkylated benzylamine derivative from Pseudomonas putida BTP1 as elicitor of induced systemic resistance in bean. Mol Plant Microbe Interact 18:562–569
Poly F, Monrozier LJ, Bally R (2001) Improvement in the RFLP procedure for studying the diversity of nif H genes in communities of nitrogen fixers in soil. Res Microbiol 152:95–103
Radjacommare R, Kandan A, Nandakumar R, Samiyappan R (2004) Association of the hydrolytic enzyme chitinase against Rhizoctonia solani in rhizobacteria-treated rice plants. J Phytopathol 152(6):365–370
Rajendran L, Samiyappan R (2008) Endophytic Bacillus sp. confer increased resistance in cotton against damping off disease caused by Rhizoctoniasolani. Plant Pathol 7:1–12
Rajendran L, Samiyappan R, Raguchander T, Saravanakumar D (2007) Endophytic bacteria mediate plant resistance against cotton bollworm. Plant Interact 2:1–10
Shrestha CL, Oña I, Muthukrishnan S, Mew TM (2008) Chitinase levels in rice cultivars correlate with resistance to the sheath blight pathogen Rhizoctoniasolani. Eur J Plant Patho 120:69–77
Slaton NA, Cartwright RD, Meng J, Gbur EE, Norman RJ (2003) Sheath blight severity and rice yield as affected by nitrogen fertilizer rate, application method, and fungicide. Agron J 95(6):1489
Solanki MK, Singh RK, Srivastava S, Kumar S, Kashyap PL, Srivastava AK (2015) Characterization of antagonistic potential of two Bacillus strains and their biocontrol activity against Rhizoctonia solani in tomato. J Basic Microbiol 55:82–90
Strobel G (2006) Harnessing endophytes for industrial microbiology. Curr opini microbiol 9(3):240–244
Suryakala D, Maheswaridevi UP, Vijayalakhmi K (2004) Chemical characterization and invitro antibiosis of siderophores of rhizosphere fluorescent pseudomonads. Indian J Microbiol 44:105108
Tamura K, Nei M, Kumar S (2004) Prospects for inferring very large phylogenies by using the neighbour-joining method. Proc Natl Acad Sci USA 101:11030–11035
Tamura K, Dudley J, Nei M, Kumar S (2007) MEGA4: molecular evolutionary genetics analysis (MEGA) software version 4.0. Mol Biol Evol 24:1596–1599
Van Loon LC (2000) Systemic induced resistance. In: Slusarenko AJ, Fraser RSS, van Loon LC (eds) Mechanisms of resistance to plant diseases. Kluwer, Dordrecht, pp 521–574
Van Loon LC, Rep M, Pieterse CMJ (2006) Significance of inducible defense related proteins in infected plants. Annu Rev Phytopathol 44:135–162
Wang H, Wen K, Zhao X, Wang X, Li A, Hong H (2009) The inhibitory activity of Bacillus sp. strain CHM1 against plant pathogenic fungi and its growth promoting effect. Crop Prot 28:634–639
Yang CJ, Zhang XG, Shi GY, Zhao HY, Chen L, Tao K, Hou TP (2011) Isolation and identification of endophytic bacterium W4 against tomato Botrytis cinerea and antagonistic activity stability. Afr J Microbiol Res 5:131–136
Zdor R, Anderson AJ (1992) Influence of colonization of cotton root colonizing bacteria on defense response of beans. Plant Soil 140:99–107
Acknowledgements
The authors are grateful to the University Grants Commission of India (UGC) for funding the project under the Major Research Project F No: 41-1169/2012 (SR) and the Department of Biotechnology, Government of India for providing instrumentation facility under the DBT-MSUB program.
Author information
Authors and Affiliations
Corresponding author
Ethics declarations
Conflict of interest
The authors hereby declare that there is no conflict of interest.
Appendix: Preparation of colloidal chitin agar
Appendix: Preparation of colloidal chitin agar
Dissolve 10 g of chitin from shrimp cells (HiMedia) slowly in 400 mL con. HCl by stirring at 4 °C and incubate the mixture in a water bath at 37 °C until viscosity disappears. To this, add 4 L sterile distilled water and leave overnight at 4 °C. Decant the supernatant slowly, collect the precipitate on a filter paper and wash extensively with sterile distilled water to attain a neutral pH. Dissolve the colloidal chitin in 250 mL distilled water prior to use.
Rights and permissions
About this article
Cite this article
Shabanamol, S., Sreekumar, J. & Jisha, M.S. Bioprospecting endophytic diazotrophic Lysinibacillus sphaericus as biocontrol agents of rice sheath blight disease. 3 Biotech 7, 337 (2017). https://doi.org/10.1007/s13205-017-0956-6
Received:
Accepted:
Published:
DOI: https://doi.org/10.1007/s13205-017-0956-6